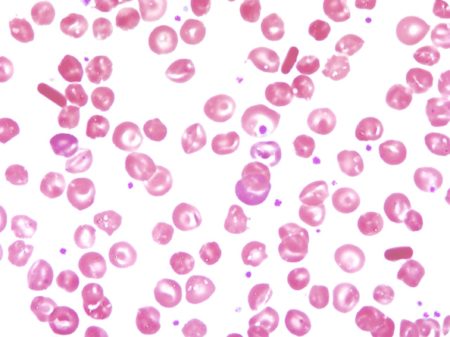

Анализ крови на RDW более известен в медицинских кругах, как анализ который позволяет определить распределение эритроцитов по объему в крови. Данные исследования позволяют в лабораторных условиях определить гетерогенность эритроцитов а также разницу размеров, которая образуется между ними.
Анализ крови на RDW более известен в медицинских кругах, как анализ который позволяет определить распределение эритроцитов по объему в крови. Данные исследования позволяют в лабораторных условиях определить гетерогенность эритроцитов а также разницу размеров, которая образуется между ними.
Отметим, что показатели объема эритроцита меняются у человека с возрастом, так как в среднем все эти показатели практически одинаковы. Если изменения появились в молодом возрасте, то это может говорить об образовании злокачественных опухолей. Встречаются случаи, когда эритроциты в крови изменяют не только свой размер, но и свою форму, в этом случае, чтобы определить причину такого поведения эритроцита необходимо сдавать анализ крови на RDW-CV и RDW-SD.
Такие анализы позволяют определить состояние дисбаланса кровеносной системы человека, и ответить на вопрос, присутствует он или все нормально.
RDW CV и RDW SD в анализе крови – расшифровка и норма
Продолжаю знакомить вас с расшифровкой сокращений, которые можно увидеть в бланке анализа, что выдает гемолитический анализатор. В данном посте пойдет разговор о таком показателе как RDW в анализе крови, или ширине распределения эритроцитов, что определяется большинством современных приборов. Это один из эритроцитарных индексов, среди которых следует назвать также MCV, MCH, MCHC.
Индекс RDW отражает неоднородность эритроцитов, является мерой несхожести популяции эритроцитов по объему и указывает на отклонения в объеме красных кровяных клеток. Коэффициент принимают на вооружение в качестве вспомогательного критерия диагностики анемий.
Содержание
- 1 RDW SD и RDW CV: расшифровки, норма, отличия
- 2 RDW в анализе крови повышен
- 3 RDW в анализе крови понижен
- 4 Что такое RDW и его разновидности (CV и SD)
- 5 Расшифровка анализа: RDW повышен
- 6 Причины снижения показателя
- 7 Для чего используют анализ?
- 8 При каких состояниях нужен анализ крови на RDW?
- 9 Как проводится забор крови?
- 10 Как подготовиться к анализам?
- 11 RDW в анализе крови: расшифровка, вариации нормы и патологии
- 12 Повышение уровня RDW
- 13 Понижение уровня RDW
- 14 Расшифровка результатов
- 15 Как проходит обследование
- 16 Причины изменения показателей
- 17 Что такое RDW
- 18 В каких случаях проводят анализ
- 19 Соотношение с MCV
- 20 Пониженный и повышенный уровни
- 21 Что определяет значение RDW
- 22 Нормальные значения RDW
- 23 Повышение ширины распределения эритроцитов
- 24 Понижение ширины распределения
- 25 Где берут ОАК с RDW?
- 26 Заключение по результатам анализа
- 27 Заключение
RDW SD и RDW CV: расшифровки, норма, отличия
С расшифровкой RDW в анализе крови ситуация немного прояснилась, но это только верхушка айсберга. Существует два показателя RDW. Это RDW-CV и RDW-SD – они оба предопределяют вариативность красных кровяных клеток по величине.
Первый индекс расшифровывается как относительная ширина распределения эритроцитов по объему (коэффициент вариации). На RDW-CV в анализе крови влияет MCV, при колебаниях которого будет наблюдаться склонность к увеличению описываемого показателя. Для того чтобы было яснее посмотрите формулу вычисления:
RDW-CV= SD/ MCV× 100
Здесь SD выступает в качестве стандартного среднеквадратического отхода объема эритроцита от среднего числа. Индекс RDW-CV указывает, насколько объем красных клеток разниться от среднего. Вымеривается он в процентах, в норме насчитывает 11,5%-14,5%, что говорит о существовании гомогенной популяции клеток (нормо-, микро- или макроцитов).
Эритроцитарный коэффициент RDW-SD в анализе крови расшифровывается как относительная ширина распределения эритроцитов по объему (стандартное отклонение). Он показывает, как сильно данные клетки несхожи по размеру и объему, то есть, какое отличие между крошечным эритроцитом и очень большим. Данный расчетный показатель не подчинен MCV, вымеривается в фемтолитрах (фл). Его норма — 42±5 фл.
Если рассматривать отличия в этих двух вариантах RDW, то следует сказать, что RDW-SD считается более точным индексом при наличии небольшой популяции макроцитов (эритроциты диаметром больше 7,9 мкм) или микроцитов (диаметр < 7,0 мкм), а RDW-CV вернее показывает общие изменения в размере красных кровяных клеток, хотя его чувствительность ниже.
RDW в анализе крови повышен
Повышение RDW более чем на 15% говорит о наличии неоднородных по объему клеток (микро-, нормо-, макро- и шизоцитов). Чем выше показатель, тем больше расхождения в размерах красных клеток. Такое явление называется анизоцитозом. Ширина распределения эритроцитов выше нормы может быть в результате многих причин, к которым причисляются:
- микроцитарные анемии;
- трансфузии крови;
- железодефицитная анемия;
- онкопатологии с метастазами в костный мозг;
- недостаточность фолиевой кислоты;
- алкоголизм;
- миелодиспластический синдром.
Повышенная ширина распределения эритроцитов наблюдается также при хронических поражениях печени (на фоне нормального MCV), отравлении свинцом, при болезни Альцгеймера, микросфероцитозе, гемоглобинопатиях, костно-мозговой метаплазии, а также при сердечно-сосудистых заболеваниях.
RDW в анализе крови понижен
Если в анализе ширина распределения эритроцитов ниже нормы, то этот факт говорит о необходимости пересдачи анализов. Потому что анализатор показывает либо завышенный показатель, либо нормальное значение. В принципе, ширина распределения эритроцитов пониженной быть не может, и такой результат не является диагностически ценным.
Надеюсь, моя статья помогла вам немного разобраться в этой достаточно непростой теме, и теперь вы знаете кое-что о расшифровке RDW в анализе крови. Попутно можете обновить в памяти информацию об эритроцитах. Если интересует их норма, то заходите сюда. Также не лишним будет прочесть о пониженных или повышенных красных кровяных клетках.
Оценить статью:
/rating_on.png)
/rating_on.png)
/rating_on.png)
/rating_on.png)
/rating_half.png)
Загрузка…
Похожие статьи:
Норма лейкоцитов в крови у женщин, мужчин и детей.
Общий, прямой и непрямой билирубин — норма в крови у женщин и мужчин
Повышенные лимфоциты в крови: что это значит и каковы причины
Что такое RDW и его разновидности (CV и SD)
RDW в анализе крови является средней величиной, показывающей ширину распределения эритроцитов по объему. Его норма составляет от 11 до 15%, то есть, в крови здорового человека допустимо наличие такого количества отличающихся от стандартных красных клеток.
RDW у ребенка может быть несколько меньше, чем у взрослого из-за наличия фетального гемоглобина, который и приводит к появлению физиологического анизоцитоза. У мужчин и женщин уровни ширины одинаковы, хотя, в некоторых случаях может наблюдаться выраженная вариация границ нормы.

Выделяют два типа данного показателя – RDW-CV, показывающий процентное распределение эритроцитов по объему, и RDW-SD, который показывает их стандартное отклонение.
RDW-SD измеряется в фемтолитрах, и показывает разность объема между наибольшим и наименьшим из выявленных эритроцитов. У женщин он характеризуется относительным постоянством, в то время как у мужчин, возможны некоторые отклонения из-за вредных привычек, более частой заболеваемости раком легких и так далее.
Следует отметить, что всегда имеется прямая связь данного индекса с другим эритроцитарным индексом – MCV (средний объем эритроцита), и именно по их соотношению можно диагностировать те или иные заболевания.
Расшифровка анализа: RDW повышен

Причины, которые могут приводить к тому, что RDW в анализе крови повышен достаточно различны.
Норма, как уже говорилось, составляет от 11 до 15%. Индекс повышается в результате появления в крови эритроцитов, не соответствующих нормальным размерам то есть, при появлении анизоцитоза. Если показатель повышен, значит, его отклонение может быть вызвано следующими причинами:
- Патология костного мозга. Различные процессы, такие как миелодисплазия, онкологические заболевания, отравление тяжелыми металлами могут приводить к изменению активности костного мозга и синтезу “нестандартных” эритроцитов. Именно данные заболевания чаще всего приводят к тому, что происходит увеличение ширины распределения эритроцитов. Иногда, несмотря на онкопроцесс, может наблюдаться норма количества красных клеток при значительном их разделении по другим морфологическим признакам.
- Недостаток фолиевой кислоты провоцирует развитие фолиеводефицитной анемии, что приводит к образованию большого количества макроцитов. В результате, норма RDW отклоняется в большую сторону, и ширина распределения изменяется. Нормализация количества данного витамина способствует тому, что восстанавливается норма показателя. У женщин такое состояние наблюдается во время беременности, из-за чего врачи рекомендуют употреблять фолиевую кислоту во время беременности.
- Гемоглобинопатии – заболевания, связанные с нарушением структуры вырабатываемого гемоглобина, например, при серповидно-клеточной анемии. В результате их развития, происходит образование клеток крови большего объема. Из-за неполноценности гемоглобина страдает транспортная функция крови, что и приводит к увеличению HB в клетке. Соответственно, ширина распределения значительно увеличивается.
Все перечисленные состояния приводят к тому, что показатель RDW увеличивается, изменяется распределение эритроцитов по объему, что негативно сказывается на состоянии организма и внутренних органов.
Причины снижения показателя

Когда показатель RDW в анализе крови понижен — означает его снижение?
Если норма смещается в меньшую сторону — значит большинство эритроцитов в крови имеют одинаковые размеры, то есть не происходит их распределения по объему и размерам.
Такое изменение можно наблюдать либо при снижении количества клеток с увеличением их размера (может наблюдаться у женщин при появлении в их крови фетального гемоглобина), либо, наоборот, при синтезе огромного количества мелких эритроцитов (ширина распределения при этом близка к нулю). Снижение встречается крайне редко, и обычно требует уточнения состояния других индексов.
Чаще всего, если ширина RDW не соответствует уменьшению MCV, значит, имеет место диагностическая ошибка, которая часто наблюдается при проведении ручного подсчета клеток. В этом случае рекомендуется повторить исследование, и если уровень вновь окажется понижен, тогда врач должен приступить к выявлению причин отклонения показателя от нормы.
Для чего используют анализ?
Анализ крови на RDW является частью общего анализа крови (ОАК). Используется для диагностики анемии — состояния, при котором эритроциты не могут переносить достаточное количество кислорода по телу. Индекс анизоцитоза эритроцитов используется для диагностики:
- Талассемии.
- Рака.
- Диабета.
- Железодефицитной анемии.
- Гепатопатии печени.

При каких состояниях нужен анализ крови на RDW?
Врач назначит общеклиническое исследование крови при стандартном плановом обследовании или если имеются:
- Симптомы анемии, включая слабость, головокружение, бледную кожу и гипергидроз.
- Семейная история талассемии, серповидно-клеточной анемии или другого наследственного расстройства гемостаза.
- Хронические заболевания: болезнь Крона, диабет или ВИЧ.
- Диета с низким содержанием железа и минералов.
- Длительная инфекция.
- Чрезмерная кровопотеря, вызванная травмой или инвазивным вмешательством.
Как проводится забор крови?
Медицинский работник возьмет образец из вены, используя небольшую иглу. Игла прикреплена к пробирке, в которой хранится образец. Когда пробирка заполнена – иглу уберут. Некоторые пациенты после укола ощущают небольшое жжение, которое продолжается 5-6 минут. После удаления иглы пациенту дадут повязку или кусок марли, чтобы остановить кровотечение.

Как подготовиться к анализам?
Анализы крови не требуют особой подготовки. Перед забором крови нельзя принимать пищу за 12 часов до начала процедуры и употреблять психотропные вещества. Исключить прием жидкости. Вышеперечисленные факторы могут исказить результаты обследования,что повлияет на постановку диагноза лечащим врачом.
RDW в анализе крови: расшифровка, вариации нормы и патологии
Важно! Расшифровка показателя RDW в анализе крови осуществляется обученным медработником или врачом. Не стоит заниматься самодиагностикой. Указанные данные предоставлены для общего развития.
Типы анемии, при которых параметр RDW в общем анализе крови остается неизменным:
- Наследственный сфероцитоз.
- Апластическая анемия.
- Некоторые виды гемоглобинопатии.
Диапазон нормы распределения эритроцитов по объему и размерам:
- RDW-SD: 39-46 фл (фемтолитры).
- RDW-CV: 10,9-15,6 у взрослых, 15,0-19,1% у детей.
RDW-SD является измерением разности объема между самым большим и самым маленьким из выявленных красных кровяных телец.КВ рассчитывается из стандартного отклонения следующим образом: коэфф. вариации (%) = 1 стандартное отклонение объема эритроцитов/MCVx100%.
Наблюдается прямая зависимость RDW от MCV (среднего объема эритроцитов). В совокупности эти два фактора используются в диагностике заболеваний различной этиологии.

Показатель RDW повышен
Если повышается значение РДВ, и снижается средний объем эритроцитов, то это свидетельствует о серповидно-клеточной анемии или дефиците железа в рационе. Апластическая анемия, хроническая болезнь печени, химиотерапия, прием противовирусных препаратов или алкоголя – причины повышения MCV. Нормальная относительная ширина распределения эритроцитов по объему в общем анализе крови и снижение MCV могут указывать на постгеморрагическую анемию или гетерозиготную талассемию. Если оба показателя выше нормы, то это говорит о дефиците витаминов группы B или миелодиспластическом синдроме. Иммунная гемолитическая анемия проявляется схожим образом.
Гиповитаминоз или авитаминоз B12 и B9 вызывает макроцитарную анемию, при которой ширина распределения эритроцитов повышена в значительной степени. Однако часто RDW в анализе крови повышен при железодефицитной анемии. У ребенка и у грудничка дефицит в рационе витаминов группы B чреват возникновением хронический анемии.
Гемоглобинопатия С, Е – заболевания, при которых нарушается нормальная структура белковой глобулы (гемоглобина). При этих состояниях кровяные тельца увеличены в размерах. Гемоглобин отвечает за транспортировку оксидов в организме.
Показатель RDW в анализе крови понижен
Если ширина распределения эритроцитов по объему ниже нормы, то это указывает на карциному костного мозга, но такое состояние является редкостью. При обильной кровопотере или инвазивном вмешательстве также понижен уровень этого показателя. У некоторых женщин в период менструации нарушается гормональный фон, что может стать причиной уменьшения ширины распределения красных шистоцитов.
Совет! Нередко анализ выдает ложноположительный результат. Это происходит из-за того, что в крови появляется много увеличенных красных кровяных телец, называемых макроцитами. Для исключения погрешностей и получения достоверных результатов может использоваться кривая Прайса-Джонса, однако этот метод не получил широкого распространения среди клиницистов.
Еще:
 Выявление анизоцитоза эритроцитов, его лечение и профилактика заболевания
Выявление анизоцитоза эритроцитов, его лечение и профилактика заболевания
 Цветовой показатель или когда говорят о гипохромии в общем анализе крови?
Цветовой показатель или когда говорят о гипохромии в общем анализе крови?
 Причины повышения и понижения средних объемов тромбоцитов, расшифровка анализа
Причины повышения и понижения средних объемов тромбоцитов, расшифровка анализа
 Показатель PDW в анализах крови, расшифровка результатов, причины повышения или понижения тромбоцитарного индекса, способы коррекции
Показатель PDW в анализах крови, расшифровка результатов, причины повышения или понижения тромбоцитарного индекса, способы коррекции
Повышение уровня RDW
Уровень RDW в исследовании крови может быть повышен в некоторых ситуациях. Самая распространенная причина такой патологии – это железодефицитная анемия.
При этом на различных этапах развития показатель будет меняться, что четко выделяется на гистограмме эритроцитарных показателей.
На начальном этапе развития анемии все индексы колеблются в нормальных пределах, а вот уровень гемоглобина будет значительно заниженным. Это говорит о здоровом функционировании спинного мозга.
На следующем этапе развития в гистограмме отмечается увеличенный уровень RDW. При проблемах с формированием гемоглобина отмечается снижение таких показателей, как средний объем красных телец, средняя концентрация и содержание гемоглобина в клетке крови.
При терапии железодефицитной анемии все действие направлено на нормализацию уровня концентрации железосодержащего белка и его характеристик в крови человека.
Такой эффект может быть достигнут при употреблении медицинских препаратов с содержанием железа.
Если уровень RDW в результате анализа крови повышен, то выделяют процесс гетерогенности всех красных телец, то есть содержание в крови различающихся по объему красных клеток или разных видов их популяции.
Такое может проявиться после переливания донорской крови.
Основные причины, провоцирующие повышение уровня RDW:
- недостаток в организме фолиевой кислоты;
- хронические болезни печени;
- патологии сердечно-сосудистой системы;
- развитие деменции;
- онкологические заболевания;
- нехватка витаминов;
- анемии различной этиологии, например, микроцитарные;
- трансфузии крови;
- алкоголизм;
- гетерогенные клональные заболевания;
- распространение метастазов в спинной мозг;
- интоксикация организма тяжелыми металлами, например свинцом;
- микросфероцитоз;
- костномозговая метаплазия;
- другие патологические состояния.
Точные первопричины может установить лишь специалист в медицинском учреждении.
Понижение уровня RDW
Чтобы разобраться в причинах пониженного показателя RDW, необходимо пересмотреть две вариации низкого показателя при соотношении двух индексов – RDW и MCV.
Первая ситуация – RDW низкий, а MCV – меньше среднего. Это сигнализирует о патологиях печени либо селезенки.
Вторая – RDW низкий, а MCV выше нормального – развитие злокачественных новообразований, вероятно, с метастазированием в костномозговую ткань.
Понижение показателя распределения красных клеток не проявляется симптоматично, поэтому в традиционной медицине при обнаружении очень низкого уровня практически всегда назначается повторное исследование крови, но с соблюдением обязательных условий:
- не употреблять спиртосодержащие напитки;
- не курить;
- не принимать лекарственные препараты;
- исключить из рациона жирную, жареную, соленую, острую и копченую пищу;
- ограничить физические нагрузки.
Если при получении повторного результата анализа оказывается, что показатели RDW и MCV неудовлетворительны, то это может сигнализировать о развитии таких патологий:
- гипохромная анемия – так называемое малокровие, вызванное преждевременной гибелью эритроцитов;
- онкологические патологии – рак молочной железы, спинного мозга;
- обширный гемолиз – заболевание, при котором красные клетки крови разрушаются настолько рано, что не приносят для организма человека пользы.
Причины, способные спровоцировать понижение RDW:
- потеря значительного количества крови при ранениях и повреждениях. Самые опасные внутренние кровотечения – это маточное и желудочно-кишечное, при которых возникает риск не только для здоровья, но и для жизни пациента;
- операбельные вмешательства, особенно из-за резекции;
- патологии пищеварительной системы, при которых пища не переваривается в полной мере, а провоцирует процесс гниения;
- гормональные колебания;
- авитаминоз;
- заболевания крови.
Предотвратить снижение показателя индекса распределения эритроцитов можно, причем сделать это довольно просто.
Во-первых, рекомендуется правильно и рационально питаться, отдав предпочтение большому количеству свежих овощей, ягод и фруктов, постному мясу и рыбе.
Во-вторых, необходимо больше времени уделять активному спорту – пробежки, велопрогулки, и даже пешие прогулки на свежем воздухе принесут большую пользу организму.
Не стоит игнорировать необходимость посещения медицинского учреждения для планового обследования.
По статистике именно на плановых осмотрах диагностируются многие заболевания, не проявляющиеся симптомами.
Расшифровка результатов
Вне зависимости от возраста пациента, анализ крови на RDW должен быть практически при одинаковых показателях. Есть определенные нормы, которые практически не допускают отклонений, только в крайних случаях могут быть допущены отклонения, но это в самых минимальных показателях.
Что касается именно результата на RDW, то здесь норма составляет от 11 до 15 %, если в данном случае результаты повышенной даже на 1-2 процента, то необходимо будет срочно обращаться к врачу за дополнительное обследованием, так как повышение процента в данном сегменте может указывать на злокачественную опухоль.
Если показатель нормальный — замечательно, а если понижен на несколько процентов, это также не говорит о том, что в организме все обстоит благоприятно. Придется обратиться также за обследованием, правда, в случае понижения результатов анализов, речь не идет об опасном заболевании. Скорее, это индивидуальные особенности человеческого организма, с которыми пациент спокойно живет.
Давайте определим более точные показатели для анализа на RDW:
- для взрослых норма составляет — 11,5-14,5%.
- для детей до полугода — 14,9-18,7%,
- для детей старше полугода -11,6-14,8%.
Как проходит обследование
Анализ крови на RDW предполагает забор венозной крови в небольшом количестве. Если речь идет о ребенке, то в данном случае кровь забирают из пальцев.
После получения биологического материала на исследование, кровь помещается в изолированный контейнер до того момента, как поступает в распоряжение лаборатории на более подробное исследование.
При транспортировке крови до лаборатории используются специальные вакуумные пробирки, которые обеспечивают чистоту материала.
Что касается процедуры забора крови, то даже при использовании вены, пациента не испытывает сильных болевых ощущений, на месте прокола через какое-то время может образоваться гематома. Происходит это у пациентов, у которых повышен гемоглобин или уровень сахара в крови. Образование гематомы не должно  вызывать у пациента беспокойства, она достаточно быстро проходит и не оставляет после себя никаких осложнений или следов.
вызывать у пациента беспокойства, она достаточно быстро проходит и не оставляет после себя никаких осложнений или следов.
Свести на «нет» практически любые болевые ощущения можно, если во время забора биологического материала потереть подушечку пальца, это касается в первую очередь маленьких детей, которые тяжело переносят болевое воздействие.
После того, как кровь попадает в лабораторию, с ней проводят исследования, а после все результаты отправляют врачу, который определяет состояние всех процессов и назначает при необходимости лечение.
В первую очередь в исследование результатов анализа обращают внимание на причину повышения уровня всех показателей и только потом необходимо уже ищут реакции, которые могут происходить или уже произошли в виду этих результатов.
В современных лабораториях используются совершенные анализаторы, которые помогают посчитать все показатели состояния эритроцитов в крови, если вдруг эритроциты в крови повышены. В данном случае проверка проводится сразу по нескольким параметрам, это и определяется в анализе крови на RDW-SD и RDW-CV .
Если у пациента все нормально с показателями, это говорит об отрицательном анализе и не требует подтверждения или повторного исследования. В противном случае, когда уровень показателей повышен, необходимо еще раз проведение контрольного исследования, которое помогает выявить истинную причину повышения, а также подтверждает правильность первоначального анализа.
Причины изменения показателей
В первую очередь повышенные показатели RDW у детей и взрослых можно наблюдать при анемиях, это может быть железодефицитная, гемолитическая и мегалобластная анемия, а также при дефиците витамина B12, и фолатов и при некоторых заболеваниях печени.
Если уровень RDW ниже нормы показателей, это говорит о развитии анемии другого типа.
Помимо этого, во время расшифровки анализа необходимо учитывать значение MCV, это помогает диагностировать и различать виды микроцитарных анемий, к примеру, если RDW нормальный, а уровень MCV понижен, то это может говорить о следующих заболеваниях:
- гемотрансфузия;
- талассемия;
- геморрагия;
- посттравматическая спленэктомия;
- злокачественные опухоли и проведенный курс химиотерапии.
 В другом случае, когда показатели противоположные, то есть МCV понижен, а RDW повышен, можно диагностировать бета талассемию, а также дефицит железа или фрагментацию эритроцитов.
В другом случае, когда показатели противоположные, то есть МCV понижен, а RDW повышен, можно диагностировать бета талассемию, а также дефицит железа или фрагментацию эритроцитов.
Различные болезни печени могут быть диагностированы, если в анализе определён повышенный MCV и нормальный RDW.
Есть еще такое состояние крови пациента, когда все показатели имеют достаточно высокие значения, в этом случае высока вероятность дефицита витамина B12, а также холодовой агглютинации, и развития гемолитической анемии. В некоторых случаях такой эффект можно наблюдать во время прохождения пациентом курса химиотерапии.
- ОБСУЖДЕНИЕ РЕЗУЛЬТАТОВ И ЗАКЛЮЧЕНИЕ
- Анализ крови при беременности: норма
- Какие бывают анализы крови
- Какая норма сахара в крови
Что такое RDW
эритроцитов
Обратите внимание, что анизоцитоз является патологическим изменением размеров (объема) эритроцитов. Если за норму принято считать 7 – 7.5 микрометров, то к отклонениям относятся макроциты (большие клетки) с размерами от 8-и до 12-и микрометров. Небольшие отклонения от нормы не являются критическими. Принято считать нормой соотношение между нормальными и измененными эритроцитами как 5:1.
Внимание.
Клинически анизоцитоз может проявляться в виде анемии, сердечной недостаточности, одышки.
И как раз RDW в анализе показывает порядок нарушения распределения эритроцитов по величине.
Особо следует подчеркнуть, что процент ширины распределения эритроцитов включает в себя два маркера:
- RDW-CV – показатель количества клеток разного объема, т.е. выраженность такого проявления, как анизоцитоз.
- RDW-SD – с помощью данного показателя происходит оценка разницы между размерами эритроцитов – от самого минимального до наиболее выраженного.
В каких случаях проводят анализ
В идеальных условиях даже в обычных поликлинических условиях при взятии крови на исследование общего клинического анализа такой показатель, как RDW и MCV, должны обязательно быть указаны. К сожалению, зачастую этого не происходит, а указанные показатели значительно могут помочь в диагностике и раннем выявлении многих заболеваний.
Данное исследование оказывает помощь при подозрении на:
- Недостаток железа, цианокобаламина, фолиевой кислоты в организме.
- Для дифференциальной диагностики талассемии от железодефицитных анемий.
- Оценка состояния организма при онкологических процессах и патологии сердечно-сосудистой системы.
Главными симптомами, на которые следует обратить внимание, а врач должен назначить анализ крови на RDW являются:
- Гипертермический синдром, особенно длительный. Без выраженных внешних признаков какого-либо заболевания.
- Недомогание.
- Утомляемость даже после полноценного сна.
- Потливость в дневное и ночное время.
- Сонливость.
- Неустойчивое настроение.
- В некоторых случаях отмечается приобретение кожей желтого оттенка.
Соотношение с MCV

При изменении показателя RDW-CV в крови будет наблюдаться повышение показателей MCV.
В отличие от CV, показатель RDW-SD не зависит от уровней MCV.
Анализ таких показателей как RDW, так и MCV, позволяет проводить качественный анализ состояния крови, а также характера патологического процесса, но который кровь дала реакцию.
Пониженный и повышенный уровни
 Ситуация, при которой RDW повышен, то есть имеем в наличии красные кровяные клетки большего, чем нужно объема, достаточно опасна. Дело в том, что одним из основных недостатков макроцитов является их укороченное время жизни. Само по себе это плохо, поскольку нужно как-то поддерживать общее количество эритроцитов в норме.
Ситуация, при которой RDW повышен, то есть имеем в наличии красные кровяные клетки большего, чем нужно объема, достаточно опасна. Дело в том, что одним из основных недостатков макроцитов является их укороченное время жизни. Само по себе это плохо, поскольку нужно как-то поддерживать общее количество эритроцитов в норме.
Но еще важнее, что увеличивается количество одномоментно распадающихся красных клеток и в результате увеличивается поток высвободившихся железа, билирубина. Этот увеличенный поток начинает загружать печень, которая теперь работает с перегрузкой.
Ко всему прочему часть макроцитов по своему диаметру не в состоянии протиснуться по диаметру капилляров и к их утилизации подключается селезенка. Нагрузка на нее приводит к ее увеличению в размерах, и селезенка начинает надавливать на кишечник и желудок. Могут пострадать окружающие ткани и органы.
Увеличение значений RDW более 15% указывает на развитие в организме патологических состояний. Наиболее часто RDW повышен бывает при:
- Сочетание с высокими показателями MCV при повышенном RDW – поражение печении при алкоголизме, гемолитическая анемия, мегалобластная анемия, гиповитаминоз витамина А.
- Сочетание с низкими показателями MCV при повышенном RDW – низкий уровень гемоглобина, железодефицитные состояния, самые начальные проявления талассемии.
- Сочетание с нормальными показателями MCV при повышенном RDW – манифестация железодефицитной анемии, понижение витамина В12 и/или фолиевой кислоты, что приводит к макроцитарной анемии.
Снижение показателей RDW ниже 10,2% встречается при наличии следующих патологических процессов в организме:
- Микроцитарная анемия.
- Ревматоидные артриты.
- Дефицит витамина В6.
- Кровопотеря.
- Нарушение всасываемости железа.
- Паразитарные инвазии.
При нормальных показателях RDW, сопровождающихся понижением MCV, говорят о:
- Частых переливаниях крови, при которых наблюдается диссоциация в образовании и наличии форменных элементов крови.
- Выраженной талассемии.
- Геморрагических процессах вследствие хронических кровопотерь, на которые организм человека не реагирует в начале заболевания никакими внешними проявлениями.
- Удалении селезенки вследствие травматических повреждений – при этом наблюдается резкое перераспределение клеток крови, а также задержка в образовании кровяных элементов из-за отсутствия одного из важных органов кроветворения.
- Злокачественных новообразованиях, при которых происходит угнетение клеточного роста системы крови.
- Проведенной химиотерапии, где, как и при проведении химиотерапевтического лечения наблюдается супрессия клеточных элементов системы крови.
- Развитие миелодисплазии.
Очень часто дебют различных заболеваний упускается ввиду недостаточной диагностики.
Своевременное, полное, а главное грамотное исследование, в первую очередь, показателей крови расскажет врачу о многих изменениях в организме человека. Это не позволит пропустить начало многих заболеваний, даже таких, как злокачественные новообразования различной локализации.
Что определяет значение RDW

Эритроцитов в крови гораздо больше других частиц. По этой самой причине, она имеет красный цвет. «Рождение» красных клеток происходит в костном мозгу. Живут они в организме недолго: от двух до трех месяцев, а умирают в печени и селезенке, благодаря «мусорщикам» фагоцитам. Некоторая часть эритроцитов растворяется в кровяном русле за счет разрушения оболочки. В организме же, они выполняют функцию доставщиков кислорода в клетки, а обратно, в легкие транспортируют углекислый газ. Имеют губчатое строение, по форме дискообразные, приплюснутые частицы, и вогнутые с обеих плоскостей.
Норма эритроцитов в крови – один из важных показателей состояния здоровья человека. Если у него не наблюдается серьезных патологий: объем, цвет и форма эритроцитов фактически одинаковая. Также не понижен CV. С течением времени, у пожилых людей наступает дисбаланс объема красных клеток.
К разнице между клетками могут привести и характерные патологии, например, анемия. За существенный показатель берется объем клеток.
Чтобы замысловатая расшифровка RDW в анализе крови стала понятна обычному человеку, требуется внести некоторую ясность. RDW — это такое исследование крови, где предопределены два взаимозависимых показателя — RDW-SD и RDW-CV. Оба они позиционируют неоднородность эритроцитов по их объему. Так, расшифровка CV обозначает относительную ширину распределения красных телец.
За величину берется объем. RDW-CV индекс документирует отклонение объема эритроцитов от среднего значения. Измерение ведется в процентах. Норма 11,5%-14,5%. Расшифровка RDW-SD, это ширина распределения клеток по объему и означает стандартное отклонение. Показатель сможет сориентировать врача о несхожести клеток по форме и объему в плане коэффициентов больших и малых эритроцитов. В целом, при наличии данных RDW-SD хорошо отслеживается индекс небольшой популяции красных клеток (измеряется в фемтолитрах). Результаты RDW-CV предоставляют картину изменений эритроцитов.
Нормальные значения RDW
Человек может сдать кровь на RDW в профилактических целях и узнать, превышена ли норма данного показателя или CV понижен. Сегодня исследование крови проводится быстро и качественно, благодаря современным анализаторам. Они вычислят средний объем эритроцитов и установят индекс RDW-CV. Норма определяется как отрицательный результат. Если ширина распределения эритроцитов повышена – назначается повторное диагностирование. Причины повышения могут быть связаны с хирургическим вмешательством или переливанием крови. При повторном анализе составляется гистограмма. Забор крови ведется:
- у младенцев из пальца;
- у взрослых из вены, в области сгиба сустава.

Кровь берется на голодный желудок. Часто сразу определяют средний объем эритроцитов, и такой показатель как ширина распределения красных клеток. Если норма превышена или индекс CV понижен – в этом случае придется обследоваться на наличие патологий, искать причины и проходить лечение.
- В шестимесячном возрасте ширина распределения должна быть 14,9-18,7%.
- Для детей старшего возраста, от полугода и дальше, индекс CV будет в пределах 11,6-14,8%.
- У взрослых норма колеблется 11,5-14,5%.
Когда RDW в анализе крови повышен, индекс может означать недостаток в организме витамина B12, болезни печени, железодефицитную анемию. В последнем клиническом случае, на различных стадиях развития патологии, RDW повышен в анализах крови неодинаково. Это можно заметить по эритроцитарной гистограмме. Так, норма эритроцитов окажется обычной, зато гемоглобин упадет до нижних значений. Далее, при осложнении будет заметно, что ширина эритроцитарной гистограммы уйдет влево, а RDW в анализе крови повысится.
Повышение ширины распределения эритроцитов
Что происходит, когда ширина распределения эритроцитов повышена. Клетки, которые увеличены в размерах, проживают недолго. Это само по себе плохо сказывается на общем количестве эритроцитов. При большом количестве разрушенных клеток образуется много железа, билирубина, который впоследствии поступает в печень для переработки. Значит, нагрузка на печень возрастает, она начинает плохо работать.
Также, когда относительная ширина распределения эритроцитов по объему повышена, увеличивается селезенка в своих размерах. Происходит это, потому что селезенка избавляется от отработанных клеток и самостоятельно пополняет кровь новыми. Нагрузка на этот орган колоссальная. Все рядом расположенные ткани и органы тоже могут пострадать. А именно, происходит надавливание на кишечник и желудок. Но если затрагиваются легкие, то может возникнуть проблема с работой дыхательных путей.
Причины, при которых распределение эритроцитов по объему повышено:
- хронические заболевания печени;
- нехватка витамина В12;
- раковые заболевания, новообразования.
Симптомы:
- желтый цвет кожи;
- повышенная температура;
- упадок сил;
- повышенное потоотделение;
- сонливость;
- смена настроения.
Частой причиной увеличения клеток является заболевание печени. От чего оно возникает?
- чрезмерное употребление соли;
- злоупотребление алкоголем;
- излишний вес;
- инфекционные болезни;
- токсины.
Когда происходит повышение распределения ширины эритроцитов, то возникает такое заболевание, как железодефицитная анемия.
При появлении болезни показатель эритроцитов не остается на месте. На первой и последующих стадиях происходят изменения. Например, в начале показатель ширины может быть в норме, а гемоглобин может быть сильно понижен, даже может достигать критических значений. Конечно, в самую первую очередь нужно привести в норму гемоглобин. Достигнуть этого можно путем принятия лекарственных препаратов, в которых достаточно большое количество железа.
Повышенное содержание эритроцитов может быть абсолютным и относительным.
Абсолютный эритроцитоз проявляется в следующих заболеваниях:
- Болезнь Вакеза, или хронический лейкоз.
- Вторичный эритроцитоз, который проявляется в форме гипоксии. Возникает вследствие кислородного голодания из-за врожденного порока сердца, повышенного содержания некоторых гормонов и рака почек и печени.
Относительный эритроцитоз – патологическое состояние, возникающее из-за:
- обезвоживания;
- стресса;
- артериальной гипертензии;
- курения и злоупотребления алкоголя.
Понижение ширины распределения
 Может возникнуть ситуация, когда анализы показали, что ширина распределения эритроцитов по объему ниже нормы. Такое бывает намного реже, чем повышение ширины.
Может возникнуть ситуация, когда анализы показали, что ширина распределения эритроцитов по объему ниже нормы. Такое бывает намного реже, чем повышение ширины.
Причины:
- большая кровопотеря;
- недостаток железа;
- недостаток витаминов;
- разрушение эритроцитов.
Распределение эритроцитов по объему понижено может быть из-за возникновения:
- злокачественных опухолей;
- лейкоза, миеломы;
- гемолиза.
Проводя исследования на анализаторе, вы увидите или повышение ширины распределения эритроцитов или норму. Связано это с тем, что очень редко ширина распределения эритроцитов понижена. Для более точного результата врач попросит сдать кровь еще раз.
Для того чтобы не допустить возникновения анемии, необходимо прислушиваться к своему организму и вести правильный образ жизни. В случае проявления первых признаков плохого самочувствия нужно обратиться к врачу. Есть такое понятие, как средняя ширина распределения эритроцитов. Она показывает, до какой степени объем эритроцитов разнится. Сдав анализы, можно узнать эту цифру.
Нарушение ширины приводит к различным серьезным заболеваниям, которые осложняются в процессе течения. Ведь если происходит сбой работы одного важного элемента организма, то это может привести к сбою в работе всей системы.
Где берут ОАК с RDW?
Основные лаборатории

Каждая уважающая себя лаборатория имеет в своём распоряжении гематологический анализатор, на котором проводится определение показателей крови. RDW как раз относится к одному из них.
Все бюджетные учреждения здравоохранения, по моему мнению, оснащены этими аппаратами. Что касается частных медицинских центров, здесь всё зависит от бюджета клиники. Если у центра есть финансовые возможности позволить себе установить гематологический анализатор, тогда к ним можно обратиться за проведением общеклинического анализа крови.
RDW входит в ряд тех показателей, которые определяются при проведении общеклинического анализа крови. Отдельно определение RDW в моей практике не встречалось.
Однако если у центра нет денег для закупки гематологического анализатора, тогда они будут отправлять ваши анализы крови в другое место, где есть возможность проведения анализа.
Учитывая тот факт, что RDW входит в общеклинический анализ крови, то цена будет та же.
При сдаче крови платно этот анализ обойдётся вам от 200 до 400 рублей. Также можно сдать его бесплатно в медицинской организации, к которой вы прикреплены.
Заключение по результатам анализа
Любые заключения и постановку диагноза может сделать только врач. Отгородите себя от самостоятельной диагностики и уж тем более от самолечения.
Индекс распределения понижен
Ситуация, когда индекс распределения эритроцитов понижен, встречается очень редко, и не имеет какой-либо клинической значимости.
Повышение индекса распределения эритроцитов
Когда RDW в анализе крови повышен, это говорит о разбросанности красных кровяных клеток по объёму. То есть могут быть и нормоциты, и микроциты, и макроциты.
Причины, которые приводят к такой гетерогенности эритроцитов, могут быть следующие:
- отравление свинцом;
- патология сердечно-сосудистой системы;
- переливание крови;
- железодефицитная анемия;
- поражение печени;
- миелодиспластический синдром.
Заключение
Мы приложили много усилий, чтобы Вы смогли прочитать эту статью, и будем рады Вашему отзыву в виде оценки. Автору будет приятно видеть, что Вам был интересен этот материал. Спасибо!





Загрузка…













































